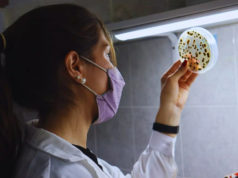
Banano: INTA evalúa control biológico para reducir fungicidas

La compañía encara su primera campaña en la Argentina con variedades que cuentan con su tecnología Enlist E3 para la zona central y el sudeste del país.
La compañía Stine presenta 5 variedades de soja para cubrir todas las necesidades de los productores en la próxima campaña.
La Stine 25EB32 es una soja 2.5 de madurez que tiene 118 días a R8. Se trata de una variedad de un enorme potencial, explosivo rendimiento ideal para el sudeste y sudoeste. Es una soja de nichos, se puede sembrar perfectamente en la zona de Venado Tuerto a fines de octubre y cosecharla temprano para ir a otro cultivo sin desmerecer el rendimiento.
La Stine 29EB02 con un grupo de madurez 2.9 y 122 días a R8 pensado para la misma zona de la primera, pero con algo más de estabilidad y no tan explosiva.
La Stine 38EB03 de grupo 3.8 y de 134 días a R8. Explosiva, de buen rendimiento y mucha estabilidad, ramifica y se trata de una variedad que para buenos ambientes no hay quien la iguale. Para ser sembrada en forma muy extensiva en la parte central, y sur de santa Fe y sur de Córdoba.
La Stine 40EB20 con una madurez 4.0 y 136 días a R8 al igual que la anterior es una variedad de ciclo intermedio, con gran estabilidad, puede ir bien en ambientes un poco más restrictivos del oeste de la provincia de Buenos Aires para siembras tempranas y también en siembras de segunda.
La Stine 48EB20, una variedad de madurez 4.8 con 140 días a R8. Muy buena variedad para ambientes más restrictivos en siembra de segunda donde manifiesta una muy buena estabilidad, una variedad que tiene muy buena agronomía.
“Stine es la propietaria de esta genética única y copropietario de la tecnología Enlist E3, un evento transgénico que le da resistencia a los herbicidas 2.4 D y glufosinato de amonio además de ser tolerantes al glifosato. Estos herbicidas no vienen a reemplazar el uso normal de preemergentes en soja, sino que buscan combatir las malezas en post emergencia sin hacerle daño a la soja. Sobre todo, con malezas más problemáticas como son la rama negra o el yuyo colorado, por ejemplo” destacó Jaime del Pino, gerente de la compañía y señaló que “debemos remarcar la diferencia de la genética y la biotecnología: primero el valor de la genética de Stine, la cual se caracteriza por su alto performance en cuanto a rendimiento y las variedades se testean bajo varios protocolos en el programa de genética de la compañía y cuentan como principal característica la búsqueda de un rendimiento superior, lo que marca si la variedad continua o se descarta del programa”.
“Para dentro de 5 años todo el mercado de soja RR va a migrar a Enlist E3, con una buena performance de rendimiento y mucho mayor espectro de uso de herbicidas. Para los próximos años la novedad es el evento Conkesta del cual también somos copropietarios, esta tecnología cuenta con 2 proteínas que le permite controlar los lepidópteros, la misma llegará al mercado para la campaña 2022/23. La idea desde Stine es que existan tanto el Enlist E3 como el Enlist Conkesta buscando que el primero sea el refugio para el efecto de este último” concluyó el ejecutivo.